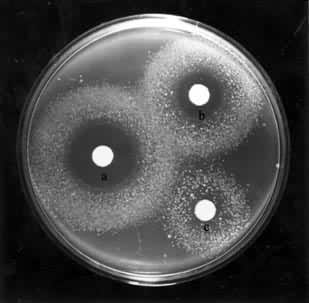
ͼ1 ��ķ˹����

[拼音]:duli yichuanxue
[外文]:toxicogenetics
或称遗传毒理学。用遗传学方法研究环境因素对遗传物质的损害及其毒理效应的遗传学分支学科。环境因素造成的遗传毒理效应包括三个方面:
(1)突变形成,环境因素诱发生殖细胞的基因突变(点突变)和染色体畸变,从而造成子代遗传性疾病发生频率的增加,②癌形成,环境因素诱发体细胞基因突变或在亲代遗传的突变形成的背景上诱发体细胞突变,引起的体细胞恶性转化为癌细胞的作用;
(3)致畸效应,环境因素作用于发育中的胚胎细胞干扰了基因的正常作用,从而影响到胚胎细胞分化和器官系统的发育而导致畸胎的发生,也包括环境因素诱发亲代生殖细胞的基因突变或染色体畸变引起畸胎的作用。致突变、致癌、致畸三者简称为毒理遗传的三致效应。在应用方面毒理遗传学的研究提供了许多迅速、准确、简便的方法来检测各种环境因素对遗传结构的危害,以便采取措施,减少这些因素对人类的危害。
简史
1927年H.J.马勒和1928年L.J.斯塔德勒用电离辐射诱发果蝇、玉米和大麦的基因突变。1951和1966年W.L.拉塞尔和B.M.卡塔纳克分别用辐射和化学物质诱发了小鼠的基因突变,并且认为人类的遗传性疾病也可能由环境因素引起。1968年J.E.克利弗发现人类的着色性干皮病病人的皮肤很易光化癌化,并且指出这是由于先天缺乏修复为紫外线诱发的DNA损伤的能力所致,并明确指出了癌症、环境因素和DNA损伤修复之间的关系。此后人们才认识到工业发达后某些物质的扩散是对人类遗传的潜在危害,毒理遗传学于是应运而生。1973年B.N.艾姆斯首创一种用细菌的回复突变作为观察指标的快速简便的检测诱变物质的方法,并且发现大约90%的致癌物质具有诱变作用。研究致突变、致癌和致畸三者之间的关系以及通过检测诱变作用来判断药物的致癌和致畸的可能性已成为毒理遗传学的理论探讨和实际应用方面的重要课题。
致突变、致畸、致癌物质的检测方法
对各种化学物质的致癌和在胚胎发育过程中的致畸效应的检测,早期的方法是用待测化学物质喂饲、注射动物或涂布在动物皮肤上,然后观查动物是否因此而患肿瘤或出现畸胎等。这种方法往往要用几种动物并重复试验才能得出可靠的结论,而且费用大,时间长。绝大部分致癌物质具有诱变作用这一发现促使人们考虑用简便的测试方法来代替动物试验。现在一般都采用细菌或离体培养的哺乳动物和人类体细胞为测试对象,主要的方法有:
以基因突变为指标的检测法在许多检测方法中以艾姆斯测验最有效。它用鼠伤寒沙门氏菌的组氨酸缺陷型(不能在没有组氨酸的培养基上生长的突变型)菌株为测试对象,如果菌株用某待测化学物质处理后能在没有组氨酸的培养基上形成菌落,就说明发生了回复突变(图1)。
根据菌落出现的数目就可以估算出该物质诱变能力的强弱。应用哺乳动物肝脏微粒体酶系(S9)作为活化系统,使待测物质先行活化,用这一模拟活体内代谢状况的措施进一步提高了检测的准确性。
以染色体为指标的方法除用经典的染色体畸变分析方法外,近年还发展了下列方法:
(1)微核测试法,以骨髓细胞或外周血淋巴细胞中微核的数量变化为指标的测试方法。各类染色体畸变中除易位、倒位或互换外一般常伴有无着丝粒断片的产生,这种断片在间期细胞的细胞质中呈现为一种圆形或椭圆形的结构──微核。因此微核出现的数目可作为染色体畸变的指标。
(2)姐妹染色单体互换测试法,在处于增殖状态的细胞培养物中添加5-溴脱氧尿嘧啶核苷(BrdU),BrdU在细胞分裂的DNA合成期(S期)的DNA半保留复制过程中参入到新合成的 DNA子链中,在BrdU持续存在两个细胞周期的情况下用吉姆萨染料对进入有丝分裂期 M期的细胞进行染色。由于在两个姐妹染色单体的一个单体中 BrdU参入了一个DNA单链,而在另一个单体中则参入了两个单链,因此两个单体间的染色便出现了色差(图2)。如果两个染色单体呈现对应的染色不连续部分,则说明姐妹染色单体间发生了互换。在相对恒定的培养条件下,每个细胞出现的姐妹染色单体互换(SCE)次数也是相对恒定的,当培养物中再添加诱变剂,就可以看到SCE显著增加(图3)。用细胞中的 SCE率来检测环境诱变剂,是一个简单、快速、灵敏的方法。该法可以应用离体培养的细胞为材料,也可应用活体细胞为材料,在离体检验中可以模拟体内情况先用微粒体酶活化系统活化待检物以进一步提高检测的可靠性。


上述各种方法各有其优缺点,艾姆斯测验简便、灵敏、快速、经济,但测试对象是原核生物,只宜对许多种类的化学物的诱变效应做初步筛选。微核法简便易行,但只限于作为染色体畸变的辅助指标。SCE 法灵敏度比常规染色体畸变分析高出成百倍,简便易行,有稳定的自发互换频率为对照,因而比较客观。但对电离辐射的敏感性却不如染色体畸变率的检测,因此仍需同染色体畸变分析结合应用。
其他还有 DNA损伤修复的检测和离体培养细胞恶性转化试验等检测方法。
应用
环境因子的监测据估计目前城市居民接触的化学物质有6万或7万种以上,随着工业的发展,每年又有上千种新的化学物质进入人类社会。用上述一系列方法结合果蝇和哺乳动物细胞的点突变(见基因突变)测验可对某一种可疑物质的遗传危害做出判断。
职业病的防治定期检查接触有毒害物质或放射性物质的工作者的外周血、尿、粪便和精液等,以便监测有害物质的遗传毒理效应。通过这些工作可以探索职业性癌症的病因,评价工业毒物的遗传危害,为制定工业毒物的最高允许浓度提供依据。
药物的临床过渡一种新的药物在临床应用前除了作一般毒理学的检测外,常需作遗传毒理的检测以便为安全用药提供依据。
目前的测试方法还不能完全排除把没有遗传毒性的物质误认为有毒(假阳性)和把有毒性的物质误认为无毒(假阴性),因此如何进一步设计采用性细胞为材料等方法,消除离体和活体测试结果的差别,提高精确度,研究各种化学物质相互作用关系和作用时相对遗传效应的影响等,都是毒理遗传学面临的研究课题。通过这些研究也必将加深对毒理遗传三致效应化学机制的认识。
- 参考书目
- David Brusick,Principles of Genetic Toxicology,Plenum Press,New York,1980.